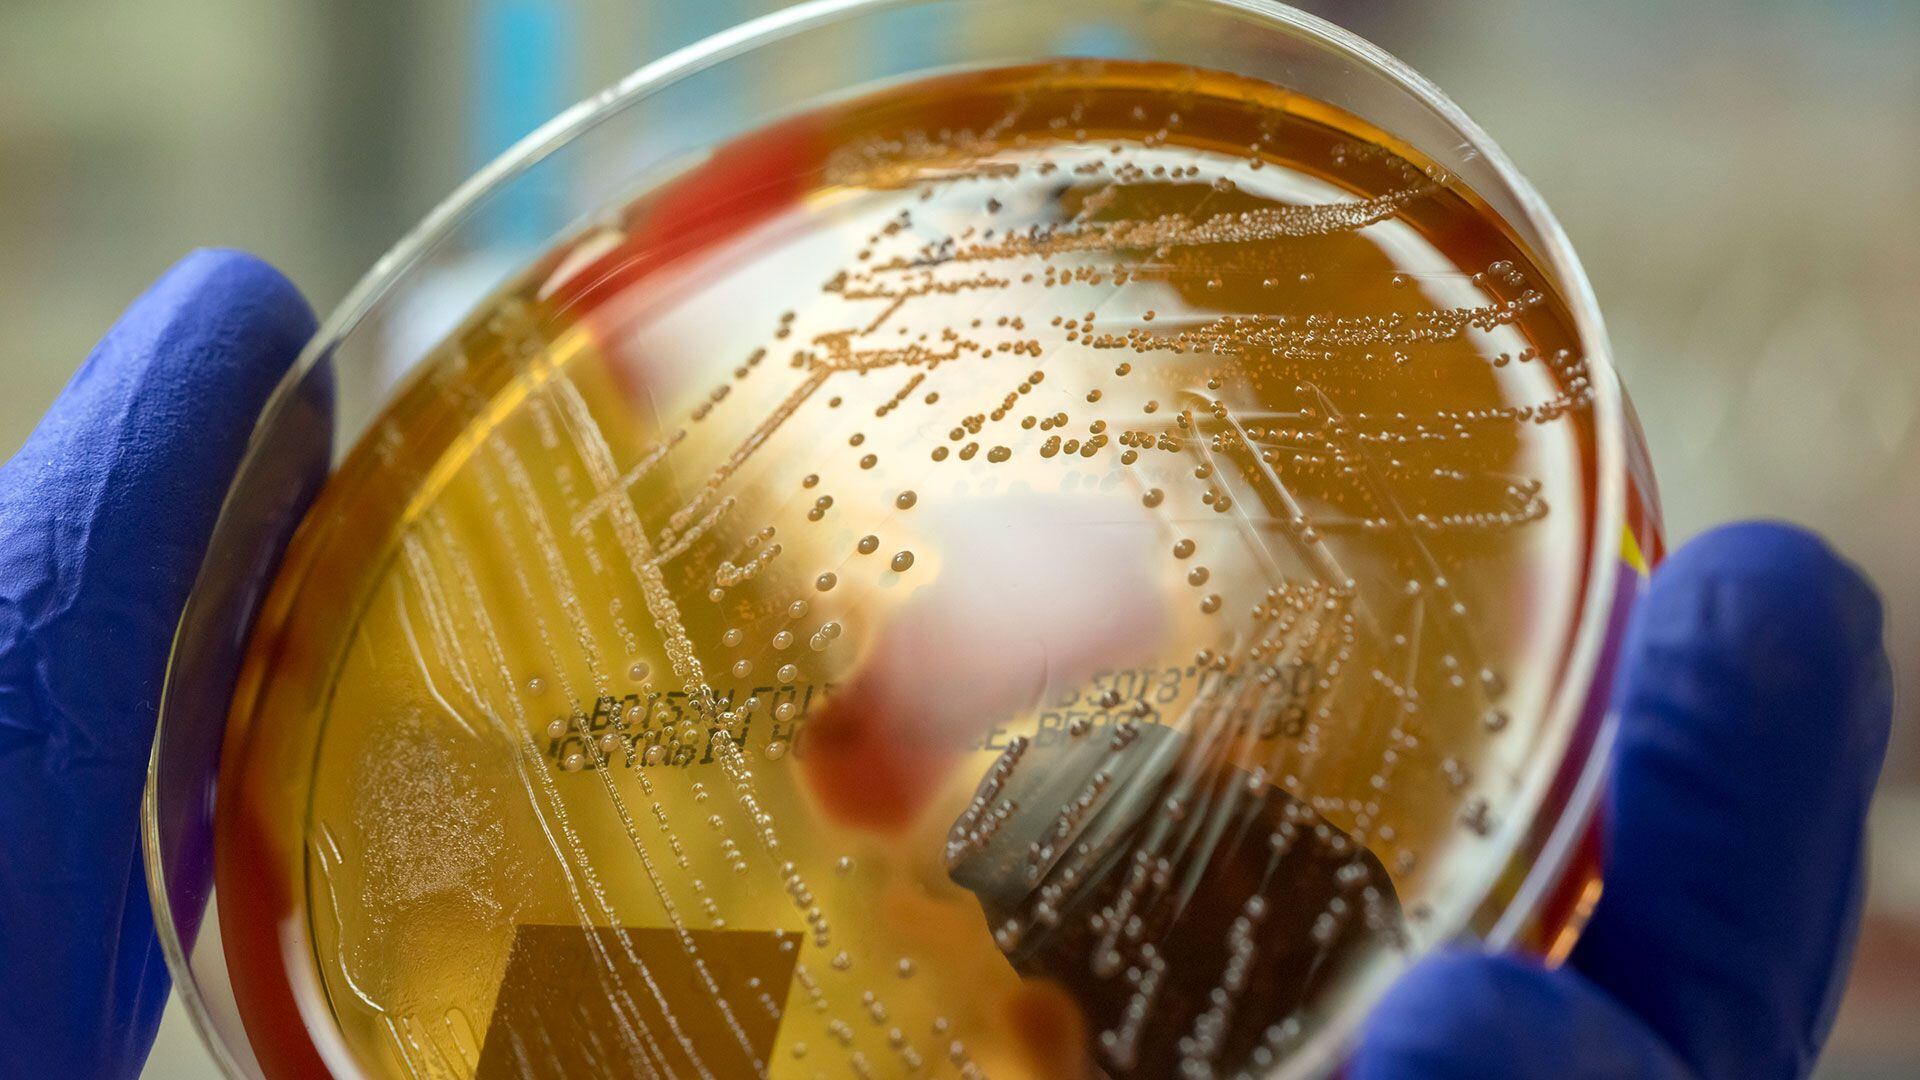

La especie Vibrio vulnificus ya causó la muerte de 13 personas en la costa este del país y los afectados se multiplicaron por ocho entre 1988 y 2018. Cómo impactan las inundaciones recurrentes en la suba de casos
Los Centros para el Control y la Prevención de Enfermedades (CDC, por sus siglas en inglés) emitieron el viernes una alerta nacional advirtiendo a los profesionales de la salud que estén atentos a las infecciones de Vibrio vulnificus, una rara bacteria carnívora que ha matado al menos a 13 personas en la costa este en lo que va del año.
:quality(85)/cloudfront-us-east-1.images.arcpublishing.com/infobae/NW6JL5HKKFBZ3GTLH3A764QBHI.jpg)
:quality(85)/cloudfront-us-east-1.images.arcpublishing.com/infobae/ZO3PWXQ3DZBETF35M7CIELFPH4.jpg)
:quality(85)/cloudfront-us-east-1.images.arcpublishing.com/infobae/EONBFHAJL5BUPMHDIFUIBCXZYM.jpg)
Aunque las infecciones por la bacteria se han reportado principalmente en la costa del Golfo, las infecciones en el este de Estados Unidos se multiplicaron por ocho entre 1988 y 2018, dijeron los CDC.
En el mismo período, el rango geográfico de infecciones del norte ha aumentado 30 millas cada año. Las infecciones de este año se produjeron durante un período de temperaturas de la superficie del mar costera superiores al promedio, dijo la agencia.
Cada año, hasta 200 personas en los Estados Unidos informan infecciones por Vibrio vulnificus a los CDC. Una quinta parte de los casos son mortales, a veces dentro de uno o dos días del inicio de la enfermedad, según la agencia.

“Las infecciones de heridas por V. vulnificus tienen un período de incubación corto y se caracterizan por una infección necrotizante de la piel y los tejidos blandos”, dijo. Los CDC dicen que muchas personas infectadas con Vibrio vulnificus “requieren cuidados intensivos o amputaciones de extremidades” y que algunas infecciones provocan lo que se llama fascitis necrotizante, una infección grave en la que muere la carne alrededor de una herida abierta.
La advertencia del viernes insta a los proveedores de atención médica a considerar la bacteria como una posible causa de heridas infectadas, particularmente si los pacientes estuvieron expuestos a aguas costeras cálidas durante los meses más calurosos.
“Los fenómenos meteorológicos extremos, como inundaciones costeras, huracanes y marejadas ciclónicas, pueden forzar las aguas costeras hacia zonas interiores, poniendo a las personas expuestas a estas aguas” en mayor riesgo de infecciones de heridas por Vibrio, dijeron los CDC.
Este año, los funcionarios de salud informaron al menos una muerte relacionada con la bacteria en Nueva York; dos en Connecticut; tres en Carolina del Norte; y siete en Florida.

Vibrio vulnificus se transmite principalmente cuando una herida abierta entra en contacto con agua salada o salobre, dijeron los CDC, y agregaron que no se ha informado de transmisión de persona a persona. Las personas con problemas de salud subyacentes, como enfermedades hepáticas, diabetes y enfermedades inmunocomprometidas, corren un mayor riesgo de infección de las heridas.
En alrededor del 10% de los casos, la bacteria infecta a quienes han comido mariscos crudos o poco cocidos. La bacteria prospera en aguas más cálidas, especialmente entre mayo y octubre, y “en ambientes marinos con bajo contenido de sal como estuarios”, según los CDC.
La agencia aconseja a las personas con una herida o corte descubierto que eviten nadar en agua salada o salobre. “Si te cortas mientras estás en el agua, sal del agua inmediatamente”, decía.
Los CDC recomiendan el uso de vendajes impermeables. Otros consejos para evitar infecciones incluyen cocinar los mariscos antes de comerlos y lavarse las manos con jabón después de manipularlos crudos.
* Por Andrew Jeong, reportero del Washington Post en su centro de Seúl, en Corea del Sur.
INFOBAE
La especie Vibrio vulnificus ya causó la muerte de 13 personas en la costa este del país y los afectados se multiplicaron por ocho entre 1988 y 2018. Cómo impactan las inundaciones recurrentes en la suba de casos
Los Centros para el Control y la Prevención de Enfermedades (CDC, por sus siglas en inglés) emitieron el viernes una alerta nacional advirtiendo a los profesionales de la salud que estén atentos a las infecciones de Vibrio vulnificus, una rara bacteria carnívora que ha matado al menos a 13 personas en la costa este en lo que va del año.
:quality(85)/cloudfront-us-east-1.images.arcpublishing.com/infobae/NW6JL5HKKFBZ3GTLH3A764QBHI.jpg)
:quality(85)/cloudfront-us-east-1.images.arcpublishing.com/infobae/ZO3PWXQ3DZBETF35M7CIELFPH4.jpg)
:quality(85)/cloudfront-us-east-1.images.arcpublishing.com/infobae/EONBFHAJL5BUPMHDIFUIBCXZYM.jpg)
Aunque las infecciones por la bacteria se han reportado principalmente en la costa del Golfo, las infecciones en el este de Estados Unidos se multiplicaron por ocho entre 1988 y 2018, dijeron los CDC.
En el mismo período, el rango geográfico de infecciones del norte ha aumentado 30 millas cada año. Las infecciones de este año se produjeron durante un período de temperaturas de la superficie del mar costera superiores al promedio, dijo la agencia.
Cada año, hasta 200 personas en los Estados Unidos informan infecciones por Vibrio vulnificus a los CDC. Una quinta parte de los casos son mortales, a veces dentro de uno o dos días del inicio de la enfermedad, según la agencia.
“Las infecciones de heridas por V. vulnificus tienen un período de incubación corto y se caracterizan por una infección necrotizante de la piel y los tejidos blandos”, dijo. Los CDC dicen que muchas personas infectadas con Vibrio vulnificus “requieren cuidados intensivos o amputaciones de extremidades” y que algunas infecciones provocan lo que se llama fascitis necrotizante, una infección grave en la que muere la carne alrededor de una herida abierta.
La advertencia del viernes insta a los proveedores de atención médica a considerar la bacteria como una posible causa de heridas infectadas, particularmente si los pacientes estuvieron expuestos a aguas costeras cálidas durante los meses más calurosos.
“Los fenómenos meteorológicos extremos, como inundaciones costeras, huracanes y marejadas ciclónicas, pueden forzar las aguas costeras hacia zonas interiores, poniendo a las personas expuestas a estas aguas” en mayor riesgo de infecciones de heridas por Vibrio, dijeron los CDC.
Este año, los funcionarios de salud informaron al menos una muerte relacionada con la bacteria en Nueva York; dos en Connecticut; tres en Carolina del Norte; y siete en Florida.

Vibrio vulnificus se transmite principalmente cuando una herida abierta entra en contacto con agua salada o salobre, dijeron los CDC, y agregaron que no se ha informado de transmisión de persona a persona. Las personas con problemas de salud subyacentes, como enfermedades hepáticas, diabetes y enfermedades inmunocomprometidas, corren un mayor riesgo de infección de las heridas.
En alrededor del 10% de los casos, la bacteria infecta a quienes han comido mariscos crudos o poco cocidos. La bacteria prospera en aguas más cálidas, especialmente entre mayo y octubre, y “en ambientes marinos con bajo contenido de sal como estuarios”, según los CDC.
La agencia aconseja a las personas con una herida o corte descubierto que eviten nadar en agua salada o salobre. “Si te cortas mientras estás en el agua, sal del agua inmediatamente”, decía.
Los CDC recomiendan el uso de vendajes impermeables. Otros consejos para evitar infecciones incluyen cocinar los mariscos antes de comerlos y lavarse las manos con jabón después de manipularlos crudos.
* Por Andrew Jeong, reportero del Washington Post en su centro de Seúl, en Corea del Sur.
INFOBAE